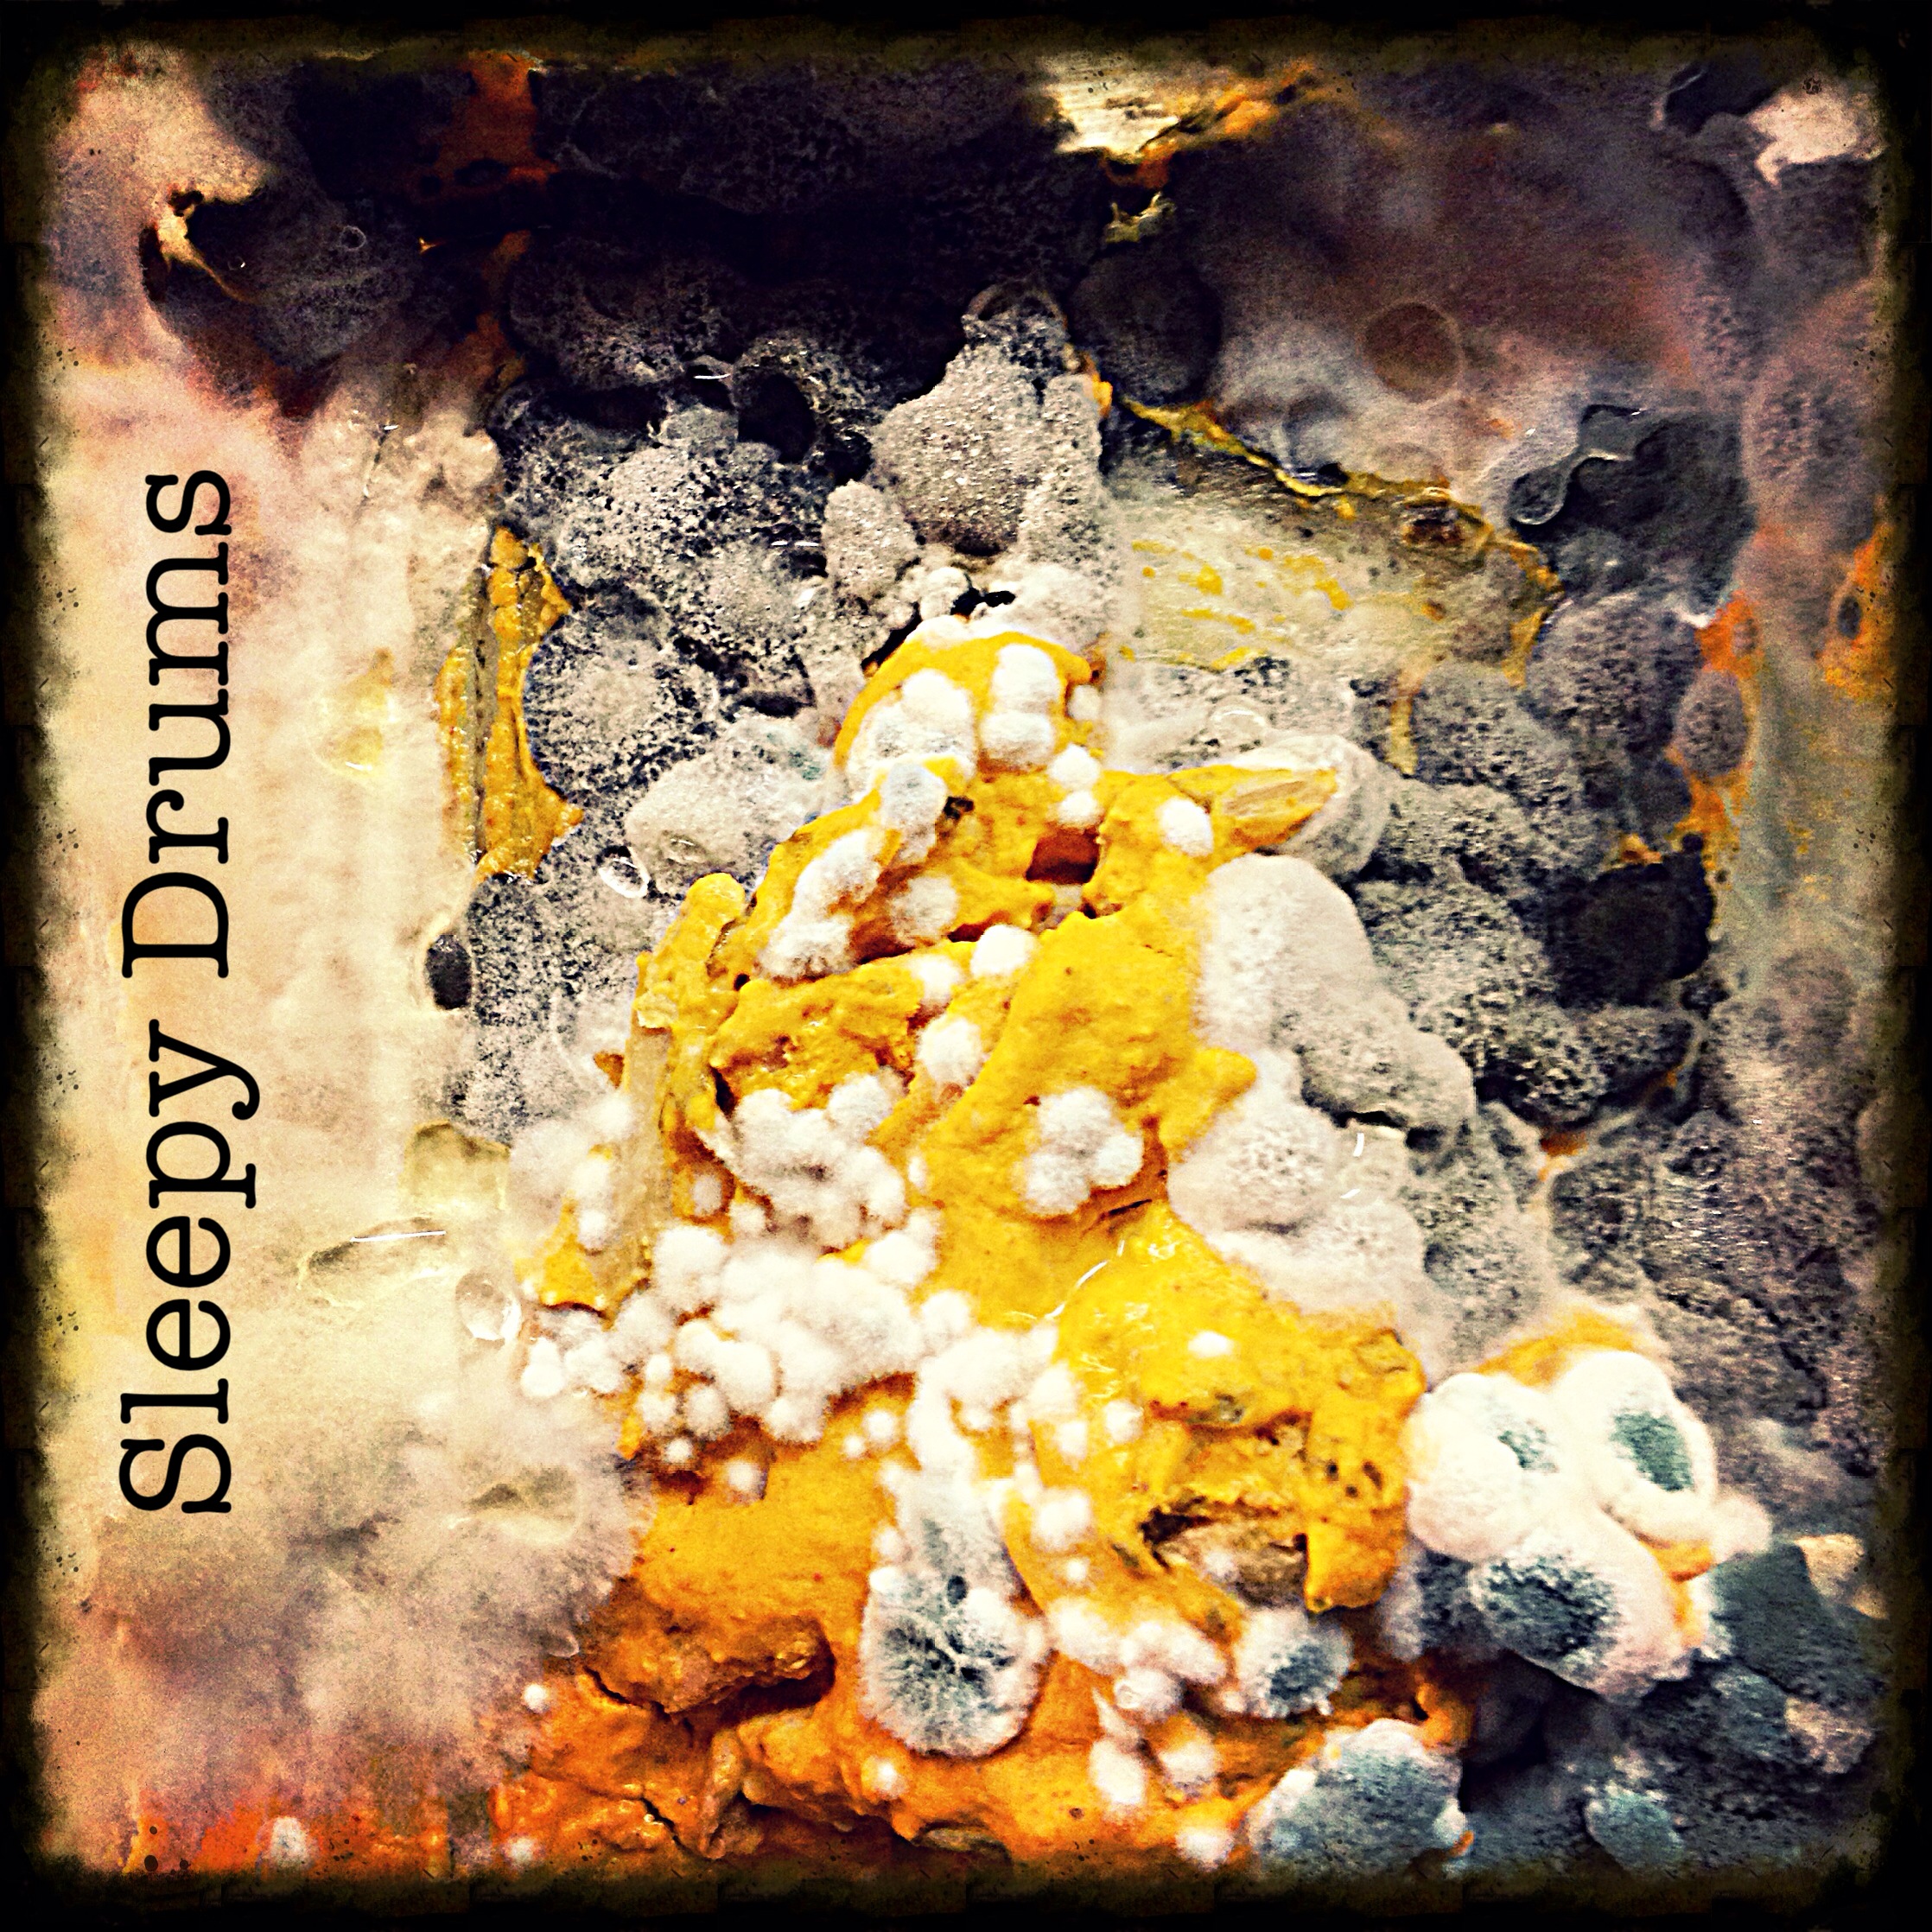

Bummer by Sleepy Drums
Tracklist
| 1. | Bummer | 2:57 |
Credits
released January 19, 2015
Written, performed and mixed by Jonathan Stout
Mastered by Alex @Go Forth Records
copyright DudeTimeTunes
Lo Fi City Records 2015
Written, performed and mixed by Jonathan Stout
Mastered by Alex @Go Forth Records
copyright DudeTimeTunes
Lo Fi City Records 2015